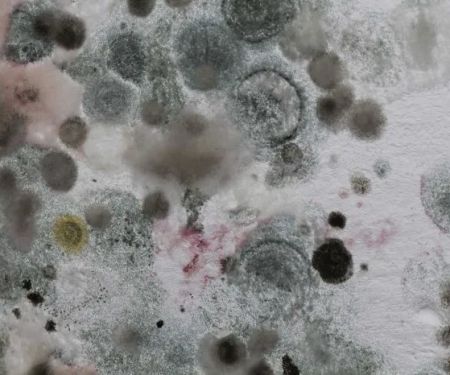
ITS Environmental Services, Inc.

Healthy Basement Systems Photos










Healthy Basement Systems Introduce
Introduction / Overview: Transforming Basements into Healthy, Usable Space Across New York
For homeowners across Long Island and the greater New York region, the basement is more than just a foundation—it represents crucial square footage and a key factor in the home’s overall health. Due to New York’s high water tables and varied climate, many local properties face persistent issues with moisture, water leaks, and foundation stress. Healthy Basement Systems in Medford, NY, is the dedicated, local expert addressing these challenges head-on.
Healthy Basement Systems is not a furniture store, despite the initial categorization; they are in fact a comprehensive home services provider specializing in "All Things Basementy." Their core mission is to transform wet, musty, and underutilized basements and crawl spaces into dry, healthy, energy-efficient, and fully finished living areas. Their expertise spans a critical range of services, including advanced basement waterproofing, foundation repair, crawl space encapsulation, and full-scale basement finishing using specialized, mold-resistant products. The entire operation is built around providing a seamless, stress-free experience, as highlighted by local customers who praise the team’s extraordinary service, attention to detail, and commitment to making the homeowner's "dream space a reality." They offer a full-circle service: fixing the underlying water issue, ensuring the structural integrity, and then beautifully finishing the space.
Location and Accessibility: Serving Long Island from Medford, NY
Healthy Basement Systems’ strategic location in Medford, New York, positions them perfectly to efficiently serve homeowners across Suffolk, Nassau, and the wider Long Island counties. This local presence ensures rapid response times and a team familiar with the unique water and soil conditions of the New York region.
Their main office and operational base are conveniently located at:
1165 Station Rd, Medford, NY 11763, USA
Accessibility is a key part of their service model, ensuring ease of access for all clients:
- Wheelchair accessible entrance
- Wheelchair accessible parking lot
For clients unable to travel or seeking initial assessment, the company also offers service options designed for maximum convenience, including:
- Online estimates
- Onsite services, bringing their expertise directly to your home for inspections and project work.
Services Offered: A Complete System for a Healthy Home Environment
Healthy Basement Systems provides a comprehensive suite of services that goes far beyond simple patch-up work. They deliver permanent, systemic solutions for the entire lower level of your property, ensuring a healthier home from the ground up. Their specialized services include:
- Basement Waterproofing Solutions: Installation of patented Interior Drain Systems (like the French Drain System), Sump Pump Installation (including the reliable TripleSafe Sump Pump System), perimeter drain systems, and basement flooding prevention.
- Foundation and Concrete Repair: Comprehensive foundation repair, including solutions for bowing walls, collapsing retaining walls, sagging or uneven floors, and the use of concrete footings, Helical Piers, and Push Pier Systems to stabilize and restore structural integrity.
- Crawl Space Health: Full Crawl Space Encapsulation System installation, Crawl Space Dehumidifier Installation (such as the Sanidry Dehumidifier), Crawl Space Drainage Systems, and Insulation to eliminate moisture, prevent mold, and improve air quality throughout the home.
- Basement Finishing and Remodeling: Installation of proprietary, waterproof, and mold-resistant finishing products, including ThermalDry® basement flooring tiles, EverLast™ Basement Wall Panels, and basement drop ceiling tiles to create beautiful, fully functional finished spaces.
- Air Quality and Moisture Control: Installation and maintenance of high-performance air filtration and purification systems, such as the Aspen Air Purifier, alongside energy-efficient dehumidifiers and moisture control services to maintain optimal indoor air quality.
- Window and Gutter Services: Installation of Egress Windows (essential for finished basements and safety code compliance), Replacement Basement Windows, and Gutter Guard Installation (like Rain Drop Gutter Guards) to manage exterior water and prevent it from reaching the foundation.
Features / Highlights: Unmatched Expertise and Customer Dedication
What truly sets Healthy Basement Systems apart in the competitive New York home improvement market are the proprietary systems they employ and the extraordinary level of customer care they provide, making them a preferred choice for local residents:
- Total Basement Finishing System™: They use and install exclusive, patented products designed specifically for the basement environment. These materials—including wall panels, flooring, and ceiling tiles—are inherently waterproof, mold-resistant, and won't rot or degrade, ensuring a beautiful, lasting finish that traditional building materials cannot match in a basement setting.
- Comprehensive Approach to Home Health: The company addresses water intrusion, structural damage, and air quality simultaneously. By combining waterproofing, foundation repair, and advanced air filter supply, they deliver a truly "healthy" home environment, tackling the damp, musty air that affects so many New York basements.
- Exceptional Customer and Project Management: Customer testimonials consistently highlight the dedication of their team members, noting that the project managers "champion" the project, remain available "no matter the day or time (even on Sunday afternoons!)", and demonstrate "patience and attention to detail is unmatched." This level of personal investment in the client’s satisfaction is a major highlight.
- Expert and Clean Installation: The work crews, often singled out by name in reviews, are praised for being "efficient and professional," working "hard, fast, and clean," and going the "extra step" to ensure flawless results with minimal disruption to the homeowner’s life.
Contact Information
For New York residents looking to solve basement moisture issues, repair foundations, or remodel their lower level into a healthy, beautiful space, Healthy Basement Systems encourages you to reach out to their experienced team.
Address:
1165 Station Rd, Medford, NY 11763, USA
Primary Phone Contact:
(631) 956-5003
Mobile Contact:
+1 631-956-5003
What is Worth Choosing: A Long-Term Investment in Your Home’s Value and Health
For New York homeowners, choosing Healthy Basement Systems is a decision to invest in the long-term health and value of their property. Living on Long Island, which is susceptible to high humidity and water issues, requires more than a temporary fix. This company offers a permanent, system-based approach—from Patented Drain Systems to the Sanidry Dehumidifier—that eliminates water problems and turns previously unusable space into a dry, functional, and aesthetically pleasing area.
The core value proposition is the transformation itself, as one customer exclaimed, "WOW, what a difference in appearance!! It truly looks like a different house!" Furthermore, the company’s commitment to extraordinary customer service—where foremen, project managers, and even office staff are praised for their caring and reliable communication—offers peace of mind during a major home improvement project. By using their specialized, mold-resistant finishing products and expert installation, Healthy Basement Systems ensures that the home's most vulnerable area becomes one of its most reliable and enjoyable.
Healthy Basement Systems Inside
Concrete Contractor
- Basement waterproofing
- Concrete footings
- Foundation drainage
- Foundation raising
- Foundation repair
- Foundations
- General repairs & maintenance
- Water & moisture control services
Window Installation Service
- General window replacement
- Basement windows
- Egress Windows
Air Filter Supplier
- Air Filter Installation
- Air Filter Maintenance
- Air Filtration
- Air Purification
- Aspen Air Purifier
- Aspen High-Performance Air Filter
Waterproofing service
- Basement Carpeting
- Basement Crack Repair
- Basement Drain
- Basement Drainage
- Basement Finishing
- Basement Flooding Prevention
- Basement Insulation
- Basement Waterproofing Contractors
- Basement Waterproofing Solutions
- Basement Waterproofing System
- Basements Dry
- Basements Leak
- Battery Backup Systems
- Bowing Walls
- Collapsing Retaining Walls
- Crawl Space Dehumidifier Installation
- Crawl Space Door
- Crawl Space Drainage Systems
- Crawl Space Encapsulation System
- Crawl Space Insulation
- Crawl Space Issues
- Crawl Space Repair
- Crawl Space Solutions
- Crawl Space Sump Pump
- Crawl Space Supports
- Crawl Space Waterproofing
- Crawl Space Winterization
- Crawlspace Drain
- Drainage Matting
- Egress Window Installation
- Energy Efficient Dehumidifiers
- Exterior Excavation
- Floor Cracks Seal
- Floor Insulation
- Free Estimate
- Free Inspection
- French Drain System
- Geotechnical Engineers
- Gutter Guard Installation
- Gutters Downspouts
- Installation Steps
- Interior Drain System
- Leaky Basement Walls
- Leaky Windows
- Moisture Control
- Mold Prevention
- Mold Remediation
- Mold Removal
- Patented Drain Systems
- Perimeter Drain
- Push Pier System
- Rain Drop Gutter Guards
- Replacement Basement Windows
- Restore Your Home
- Sagging Floors
- Sanidry Dehumidifier
- Seal Block Walls
- Seal Wall Cracks
- Sealing A Basement
- Slab Piers
- Steps Repair
- Stone Walls
- Sump Pump Installation, repair, and maintenance
- Sump Pump Replacement
- Sump Pump Systems Installation
- Support Jacks
- Thermal Insulation
- Triplesafe Sump Pump System
- Uneven Floors
- Vapor Barrier System
- Vent Covers
- Wall Braces
- Wall Covering
- Wall Reinforcing Systems
- Wall Repair System
- Walls Replacement
- Water Leaking
- Waterproofing Products Installed
- Waterproofing Specialists
- Waterproofing Wall
- Wet Basement Repair
- Window Repair
- basement drop ceiling tiles
- basement floor decking
- basement wall panels
- bilco doors
- wall restoration
Insulation Contractor
- Air sealing
- Insulate Crawl Space Floor
- Rigid Foam Insulation
Foundation
- Foundation Repair
- Foundation Wall Reinforcing
- Foundation Wall Repair
- Foundation Wall Restoration
- Helical Piers
- Push Piers
- Street Creep Repair
- foundation piers
Carpet Installer
- ThermalDry® basement flooring
- Waterproof Basement Flooring Tiles
- basement carpeting
- install your basement flooring tiles
Gutter service
- gutter guard installation
- gutter guards
- gutter service
- rain drop gutter guard installation
Healthy Basement Systems Details
Service options
- Online estimates
- Onsite services
Accessibility
- Wheelchair accessible entrance
- Wheelchair accessible parking lot
Healthy Basement Systems Location
Healthy Basement Systems
1165 Station Rd, Medford, NY 11763, USA
Healthy Basement Systems Reviews
crawl spacequestionsdehumidifiersystem designpresentationforemansalespersonpressureeducationalmario
★ 5★ 4★ 3★ 2★ 1Due to living on the water, I needed a French drain system and sump pump to keep my basement dry & livable… Ended up doing laminate flooring and walling called “clean space” WOW, what a different in appearance!! I’m enormously happy with the intense journey of redoing my entire basement! It truly looks like a different house! Special shout out to Joe and to Chris when it came to all of the technicals & and advice! Their patience and attention to detail is unmatched. Both Joe and Chris were always available by phone to assist with questions and even came in person several times to check on the progress.Additionally, a major shout out to David and Mikey, who were efficient and professional; installing the flooring that looks perfect & even took an extra step to make the clean space (white wall) be more taut!! If nothing else, this company definitely wants to do the right thing by you!! Thanks so much David and Mikey - you guys nailed it!!This was a huge job and I am thrilled with the results.
Aug 16, 2025 · Lindsey CreeganFrom start to finish, my experience with Healthy Basement has been nothing short of extraordinary. What began as a simple basement project quickly became the space of my dreams—a warm, beautiful, and functional area where I can enjoy quality time with my family. This transformation was only possible because of the exceptional team who poured their heart, skill, and dedication into the job.Eric Robles – Foreman ExtraordinaireEric Robles, the foreman on my project, quickly became more than just a contractor—he became someone I could trust completely. His attention to detail, craftsmanship, and genuine passion for his work was evident every single day. Eric took his time to make sure every finish was flawless, advocating for me whenever a decision needed to be made. I could tell he truly cared about the end result as much as I did.Christian Robles – Tireless Worker with True DedicationWorking alongside Eric was Christian Robles, whose work ethic blew me away. There were days he worked straight through lunch just to keep things on track. His commitment to making sure the job was done right was inspiring, and his efforts never went unnoticed.Chris Seager – The Project Manager Who Made the Impossible PossibleIf there’s one person who deserves endless praise, it’s Chris Seager. Chris didn’t just manage my project—he championed it. When I faced severe plumbing problems and was initially told nothing could be done, Chris refused to accept defeat. He personally called me, promised help within the hour, and sure enough, Mike from Tumminello Plumbing & Heating showed up and resolved the issue. That moment changed everything for my project.From that point on, Chris became not only my project manager but also a friend. He visited my home every single day to check in on progress, responded to messages no matter the day or time (even on Sunday afternoons!), and never made me feel like my questions or changes were a burden. Despite the pressure from my many modifications to the project, Chris always found a way to make it work. His customer service skills, problem-solving ability, and genuine care for my satisfaction are unmatched. I can say without hesitation: I have Chris to thank for making my dream space a reality.Mike from Tumminello Plumbing & HeatingMike’s quick arrival and expert work on my plumbing crisis was nothing short of heroic. He solved an issue that others had said was impossible, and his role in this transformation will never be forgotten.The Egress Window Installation TeamAnother standout part of the project was the egress window installation team. They worked hard, fast, and clean, leaving absolutely no damage and delivering a perfect result. Their professionalism and efficiency were top-notch.Dave – The Reliable Backup ForemanDave, who stepped in at times as foreman, also deserves credit. He communicated clearly, kept me updated, and ensured the project continued to run smoothly whenever he was involved.Final ThoughtsHealthy Basement didn’t just renovate my basement—they gave me a space I fall more in love with every single day. I will recommend them to everyone I know, and as I’ve already told Chris, I’ll be telling people to request him specifically—because I know he will make their dream come true just as he did mine.Thank you, Chris. Thank you, Eric. Thank you, Christian. Thank you, Mike. And thank you to every single person at Healthy Basement who made this project such a joy.
Aug 13, 2025 · Steven SeraphinI love the work that Carlos Ramirez and his crew have done on my basement. I had it waterproofed. I am satisfied with the installation of my 3 windows, the outside window wells, and my humidifier. I had paneling on the walls and everything was stripped. The work was completed in two days! I am so appreciative of Healthy Basement Systems. Thank you!PS...It took me a while and I would be remiss if I did not thank the person who turned me on to the Healthy Basement Systems in the first place. This is a shout-out to Nicholas Church. I could not locate his card. Nick is now involved with the company in the next step after this, the completion of a finished basement. So please contact Nicholas for yourfinished basement and his expertise.Contact Healthy Basement Systems to get your project started!
Jul 20, 2025 · Nina TribbleAdrian, Alex and Mikey introduced themselves upon arrival. With the exception of the drilling, we were unaware of their presence. The waterproofing was completed professionally and with care. Questions were answered to my satisfaction. After completion the team explained the system to us. We are hoping that Healthy Basement Systems will provide us with a healthier dryer space.
Sep 23, 2025 · Sharon MeadeThe crew just left - Carlos Ramirez team.Very impressed with professionalism, cleanliness and detail to work. Explained all details, operations, warranty, etc.Great job HBS. Done well. And special shout out to Eric Greenberg who made it all happen. I would recommend.
Jul 17, 2025 · Wayne Bennett
More Water Damage Restoration Near Me
ITS Environmental Services, Inc.5.0 (22 reviews)
ITS Environmental Services, Inc.5.0 (22 reviews)78 Horseblock Road Unit 7, Yaphank, NY 11980, USA
 ServiceMaster by American Restoration Services4.0 (40 reviews)
ServiceMaster by American Restoration Services4.0 (40 reviews)22 Scouting Blvd, Medford, NY 11763, USA
 Diamond Cut Restoration5.0 (25 reviews)
Diamond Cut Restoration5.0 (25 reviews)450 Patchogue-Yaphank Rd, Yaphank, NY 11980, USA
 KOS Restoration5.0 (311 reviews)
KOS Restoration5.0 (311 reviews)11 Farber Dr Unit F, Bellport, NY 11713, USA
 SERVPRO of Patchogue, Brookhaven4.0 (96 reviews)
SERVPRO of Patchogue, Brookhaven4.0 (96 reviews)2801 Montauk Hwy Unit D, Brookhaven, NY 11719, USA
 Bulovas Restorations5.0 (34 reviews)
Bulovas Restorations5.0 (34 reviews)115 Mt Vernon Ave, Patchogue, NY 11772, USA
 SERVPRO of Medford4.0 (48 reviews)
SERVPRO of Medford4.0 (48 reviews)3090 NY-112, Medford, NY 11763, USA
 Water Damage Removal Suffolk County5.0 (3 reviews)
Water Damage Removal Suffolk County5.0 (3 reviews)22 N Dunton Ave, Medford, NY 11763, USA
 Healthy Buildings & Homes5.0 (42 reviews)
Healthy Buildings & Homes5.0 (42 reviews)116 West Ave, Patchogue, NY 11772, USA
 Gold Tech Property Restoration0.0 (0 reviews)
Gold Tech Property Restoration0.0 (0 reviews)60 Waverly Ave, Patchogue, NY 11772, USA
 Rapid Restoration5.0 (132 reviews)
Rapid Restoration5.0 (132 reviews)429 W Main St, Patchogue, NY 11772, USA
 SERVPRO of Port Jefferson4.0 (181 reviews)
SERVPRO of Port Jefferson4.0 (181 reviews)501 Middle Country Rd, Coram, NY 11727, USA
Categories
Top Visited Sites
 380 Companies4.0 (104 reviews)
380 Companies4.0 (104 reviews) Zeppelin Cleaning Services5.0 (1694 reviews)
Zeppelin Cleaning Services5.0 (1694 reviews) Ultra Hygiene Services (UHS Mold)5.0 (21 reviews)
Ultra Hygiene Services (UHS Mold)5.0 (21 reviews) Water Damage Helper NY5.0 (6 reviews)
Water Damage Helper NY5.0 (6 reviews) Radar Restoration LLC4.0 (34 reviews)
Radar Restoration LLC4.0 (34 reviews) Southern Technologies4.0 (11 reviews)
Southern Technologies4.0 (11 reviews)Top Searches
Trending Damage Repair Guides Posts
 Water Damage Repair for Subflooring Under Carpets
Water Damage Repair for Subflooring Under Carpets How to Handle Water Damage After a Storm: A Step-by-Step Guide
How to Handle Water Damage After a Storm: A Step-by-Step Guide Water Damage Restoration for Restaurants and Food Service Areas – A Complete Guide
Water Damage Restoration for Restaurants and Food Service Areas – A Complete Guide How to Deal With Water Damage From Roof Ice Dams: Prevention and Repair Tips
How to Deal With Water Damage From Roof Ice Dams: Prevention and Repair Tips What to Do if Your Roof Is Leaking and Causing Water Damage Inside
What to Do if Your Roof Is Leaking and Causing Water Damage Inside How to Restore Water-Damaged Rugs and Carpets
How to Restore Water-Damaged Rugs and Carpets 
